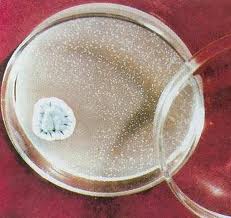

El próximo lunes, se celebra en España, el día de la Constitución. Es muy importante saber por qué celebramos esta fiesta y en qué consiste dicho documento y los símbolos en los que se sustenta nuestro Estado. Le damos las gracias a Óscar Sánchez que ha realizado este estupendo trabajo.
http://www.authorstream.com/Presentation/oscarensanche-280503-constituci-espa-ola-para-ni-os-education-ppt-powerpoint/
Bienvenidos a nuestra ventana al mundo. Damos las gracias a todas las personas que hacen posible que tengamos estos enlaces educativos tan estupendos.
martes, 30 de noviembre de 2010
Aprende a estudiar
Vamos en el buen camino para aprender a estudiar, aunque este camino es largo resulta apasionante. Mi amiga y maestra Pilar Salaverría, ha publicado en su blog este enlace que nos va a ayudar mucho, seguro.
.http://www.isftic.mepsyd.es/w3/eos/MaterialesEducativos/mem2006/aprender_estudiar/index2.swf
.http://www.isftic.mepsyd.es/w3/eos/MaterialesEducativos/mem2006/aprender_estudiar/index2.swf
Un experimento casero
¿Quieres hacer un experimento fácil en casa?. Aquí tienes uno nada peligroso. A ver que conclusiones sacas
lunes, 29 de noviembre de 2010
Alexander Fleming
Nació el 6 de agosto de 1881 en Lochfield ,Gran Bretaña, de una famila campesina afincada en la vega escocesa. A los 20 años, la herencia de un pequeño legado le llevó a estudiar medicina, obtuvo una beca durante cuarenta años. En 1908 se licenció, obteniendo la medalla de oro de la universidad de Londres. Nombrado profesor de bacteriología, en 1928 pasó a ser catedrático , retirándose como emérito en 1948, aunque ocupó hasta 1954 la dirección del Wright-Fleming Institute of Microbiology fundado en su honor y en el de su antiguo maestro y amigo.
La carrera profesional de Fleming estuvo dedicada a la investigación de las defensas del cuerpo humano contra las infecciones bacterianas. Su principal e importantísima aportación fue el descubrimiento de la PENICILINA que ha salvado miles y miles de vidas. Murió el 11 de marzo de 1955. GRACIASCarmen y Marina
domingo, 28 de noviembre de 2010
LA SUPERCARRERA DE LA ORTOGRAFÍA
Te va a encantar esta lucha sin cuartel contra los errores ortográficos. Tú contra una súper de la ortografía. ¿Quién ganará?. Para saberlo, pincha en el enlace y no te despistes ni un momento.
http://www.supersaber.com/homofonasBV.htm
http://www.supersaber.com/homofonasBV.htm
sábado, 27 de noviembre de 2010
Los cambios de estado de la materia
Diviértete con esta wiki sobre los cambios de estado de la materia.
http://www.wikisaber.es/Contenidos/LObjects/reactions_of_materials_1/index.html
http://www.wikisaber.es/Contenidos/LObjects/reactions_of_materials_1/index.html
El agua
http://www.educa.madrid.org/web/cp.claracampoamor.fuenlabrada/flash/juegos/agua/11.swf
Ahora que vamos a empezar un nuevo tema, ve preparándolo con esta presentación, cogida del blog de mi compañero Amado Martínez. Gracias Amado
Ahora que vamos a empezar un nuevo tema, ve preparándolo con esta presentación, cogida del blog de mi compañero Amado Martínez. Gracias Amado
viernes, 26 de noviembre de 2010
Louis Pasteur
Louis Pasteur nació el 27 de diciembre de 1822 y murió el 28 de septiembre de 1895. Fue un químico francés cuyos descubrimientos tuvieron enorme importancia en diversos campos de las Ciencias Naturales, sobre todo en la Química y Microbiologia. A él se debe la técnica de la pasteurización, el proceso que actualmente garantiza la seguridad de numerosos productos alimenticios del mundo.
En 1871 sugirió a los médicos de los hospitales militares que hirviesen el instrumental y los vendajes.
Pasteur desarolló la metodología para atenuar la virulencia de microorganismos patógenos que pudieron ser entonces utilizados para la fabricación de vacunas.Él mismo obtuvo vacunas eficaces contra el cólera de los pollos, el ántrax y la erisipela del cerdo.
Posteriormente obtuvo la vacuna contra el virus de la rabia, que fue un digno clímax a su asombrosa carrera científica. GRACIAS.
Guillermo y Lorena
Guillermo y Lorena
Personas importantes para la Humanidad
Innauguramos hoy una de nuestras secciones. Va a ser de hombres y mujeres que han sido muy importantes para la Humanidad, normalmente porque sus investigaciones y logros han mejorado nuestra vida, el tratamiento de la enfermedades etc... Además, algunos de ellos son químicos, ya que se acerca el año internacional de la Química, y que en nuestro cole lo celebraremos de alguna forma, seguro.
jueves, 25 de noviembre de 2010
La Antártida.
Estos días hemos aprendido un poco más de esta zona de la Tierra y de los que ahí trabajan. Este vídeo seguro que te gustará
miércoles, 24 de noviembre de 2010
Escribimos sobre :"El calentamiento global"
Vas a tener que escribir acerca del "Calentamiento global", de como han ido cambiando las temperaturas y el tiempo atmosférico estos últimos años. Para ello contarás con tus conversaciones con las personas de tu entorno, tus padres, tus abuelos... que te contarán si es diferente el tiempo atmosférico ahora y cuando ellos eran pequeños, y también con la ayuda de material más científico, como este video. Luego saca tú tus propias conclusiones y prepara tu redacción
martes, 23 de noviembre de 2010
lunes, 22 de noviembre de 2010
domingo, 21 de noviembre de 2010
sábado, 20 de noviembre de 2010
Profundizando en los ecosistemas
http://cienciasnaturales.es/REDACUATICA.swf
Pincha sobre el enlace debajo de la imagen, para saber más sobre los ecosistemas.
Pincha sobre el enlace debajo de la imagen, para saber más sobre los ecosistemas.
viernes, 19 de noviembre de 2010
ME LO HAN CONTADO MIS ABUELOS
Nosotros, los kintos, hemos hecho un libro que se titula "Me lo han contado mis abuelos " . Cada uno hemos hablado de algunas historias que les pasó de pequeños a los abuelos.!Fue un trabajo divertido!
Un abrazo David
Un abrazo David
LAS ADIVINANZAS
Nosotros los kintos hemos hecho un libro de adivinanzas, ¡72 adivinanzas !Algunas fueron fáciles de adivinar, pero otras fueron difíciles. ¡Fue un trabajo divertido!
jueves, 18 de noviembre de 2010
miércoles, 17 de noviembre de 2010
LOS DERECHOS DE LOS NIÑOS
El día 20 de noviembre, rememoramos la declaración Universal de los "Derechos de los Niños". Hemos aprovechado en la clase para reflexionar sobre todos aquellos niños del planeta que sufren cada día y así valorar más lo nuestro.
Aquí va un pequeño resumen de los principios de esta declaración:
Aquí va un pequeño resumen de los principios de esta declaración:
- DERECHO A LA IGUALDAD, SIN DISTINCIÓN DE RAZA, CREDO O NACIONALIDAD.
- DERECHO A UNA PROTECCIÓN ESPECIAL PARA SU DESARROLLO FÍSICO,MENTAL Y SOCIAL. (VÍCTOR Y JERRY)
- DERECHO A UN NOMBRE Y UNA NACIONALIDAD. (SIMÓN Y ROCÍO)
- DERECHO A UNA ALIMENTACIÓN, VIVIENDA Y ATENCIÓN MÉDICA ADECUADAS PARA EL NIÑO Y LA MADRE (IRENE Y ALMA)
- DERECHO A UNA EDUCACIÓN Y CUIDADOS ESPECIALES PARA EL NIÑO FÍSICA O MENTALMENTE DISMINUIDO. (SHEILA Y SAYRA )
- DERECHO A COMPRENSIÓN Y AMOR POR PARTE DE LOS PADRES Y LA SOCIEDAD(LORENA Y MARIA BELÉN)
- DERECHO A RECIBIR EDUCACIÓN GRATUITA Y A DISFRUTAR DE LOS JUEGOS(MELANIE Y SANDRA )
- DERECHO A SER EL PRIMERO EN RECIBIR AYUDA EN CASO DE DESASTRE (CAROLINA Y SANDRA)
- DERECHO A SER PROTEGIDO CONTRA EL ABANDONO Y LA EXPLOTACIÓN EN EL TRABAJO
- DERECHO A FORMARSE EN UN ESPÍRITU DE SOLIDARIDAD, COMPRENSIÓN, AMISTAD Y JUSTICIA ENTRE LOS PUEBLOS. (DIEGO)
lunes, 15 de noviembre de 2010
Experimentos
Los huevos divertidos.
En clase hemos traído unos huevos que en ellos hemos plantado lentejas y alpiste. La finalidad es hacer un trabajo manual diferente.Al final crecerán las lentejas y el alpiste y como hemos pintado unas caras quedarán muy bien.
Un beso gracioso Sandra Vicién
Todo sobre mi madre
Quizá la persona o una de las personas más importante para todo el mundo, sea nuestra madre. Por eso les estamos escribiendo un libro, que se va a titular todo sobre mi madre.
Iremos colgando aquí las frases que nos gusten más de nuestras redacciones.
Pilar
Iremos colgando aquí las frases que nos gusten más de nuestras redacciones.
Pilar
domingo, 14 de noviembre de 2010
Abrimos nuestra clase al mundo
Hola queridos Kintos y planeta en general.
Hoy estrenamos nuestro nuevo blog. Se llama "investigadores", porque eso es lo que hemos hecho desde el principio de curso, investigar a tope, descubrir cosas y personas nuevas, abrir nuestra mente al mundo para conocer mejor cómo son las cosas y las personas que nos rodean. Esta herramienta es una buena forma de contarle al mundo lo que pasa dentro de nuestra clase y dentro de la cabeza de cada uno de nosotros.
Por eso os invito a todos a escribir vuestras experiencias, lo que descubrís cada día. Lo que aprendéis y lo que os gustaría aprender.
A partir de hoy, podemos decir que estamos presentes en el mundo virtual de la red.
Un beso. Pilar
Hoy estrenamos nuestro nuevo blog. Se llama "investigadores", porque eso es lo que hemos hecho desde el principio de curso, investigar a tope, descubrir cosas y personas nuevas, abrir nuestra mente al mundo para conocer mejor cómo son las cosas y las personas que nos rodean. Esta herramienta es una buena forma de contarle al mundo lo que pasa dentro de nuestra clase y dentro de la cabeza de cada uno de nosotros.
Por eso os invito a todos a escribir vuestras experiencias, lo que descubrís cada día. Lo que aprendéis y lo que os gustaría aprender.
A partir de hoy, podemos decir que estamos presentes en el mundo virtual de la red.
Un beso. Pilar
Suscribirse a:
Entradas (Atom)